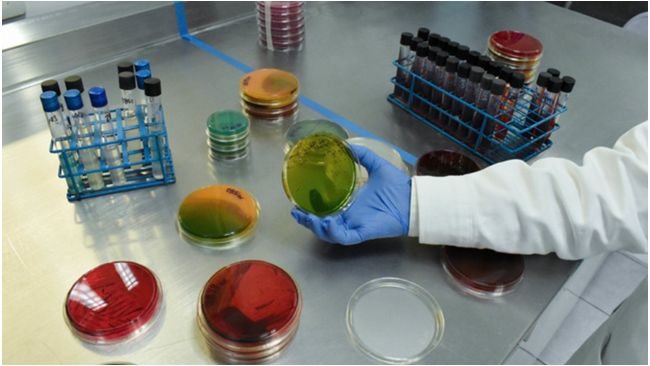

UE: respuesta unificada a la resistencia a los antibióticos
La Comisión Europea lanza EU-JAMRAI 2 para dar una respuesta unificada a la resistencia a los antibióticos.
Noticias, eventos y reportajes de actualidad del sector porcino
Los eventos del sector porcino que se organizan en todo el mundo
Un resumen semanal de las novedades de 3tres3 Latam
Boletín de noticias sobre el mundo del porcino
La salud de los cerdos: noticias y artículos sobre PRRS, PCV2, bioseguridad, etc., guía de enfermedades del cerdo, atlas de patología, casos clínicos...
Cómo realizar una necropsia en un cerdo, paso a paso, de una forma muy visual y práctica.
Biocheck.UGent es un sistema de puntuación científico independiente, basado en riesgos, para evaluar la calidad de su bioseguridad en la granja.
Toda la información sobre la PPA
Descripción de las enfermedades y afecciones más importantes en cerdos
Lesiones y signos de las principales enfermedades del cerdo
Herramienta para diagnosticar enfermedades del cerdo
Un diccionario sobre terminología específica de la porcicultura
Calcula la cantidad de medicamento a incorporar en el agua cuando usamos un dosificador de flujo
Un resumen semanal de las novedades de 3tres3 Latam
Precios del cerdo por países. Producción y comercio de carne de cerdo. Noticias del mercado porcino y las materias primas
Últimas cotizaciones de los mercados mundiales más importantes del cerdo. Históricos de precios en diversas monedas y en formato gráfico.
Últimas cotizaciones de las principales materias primas para alimentación de cerdos. Históricos, precios del cerdo y estimación del precio del alimento.
Datos de censos, producción de carne de cerdo, número de granjas, etc.
Datos de producción y comercio mundial de las principales materias primas utilizadas en la alimentación de cerdos
Un resumen semanal de las novedades de 3tres3 Latam
Artículos sobre nutrición y alimentación de cerdos, características de las materias primas y aditivos para porcinos y precios de las materias primas
Últimas cotizaciones de las principales materias primas para alimentación de cerdos. Históricos, precios del cerdo y estimación del precio del alimento.
Datos de producción y comercio mundial de las principales materias primas utilizadas en la alimentación de cerdos
Fichas técnicas de las principales materias primas y aditivos. Incluyen información de valores nutricionales, producción y comercio, estudios recientes, ...
Un diccionario sobre terminología específica de la porcicultura
Utiliza esta herramienta para diagnosticar problemas con el índice de conversión. Haz click en el diagrama de flujo o en los botones dentro del texto para navegar por las distintas partes de la herramienta.
Un resumen semanal de las novedades de 3tres3 Latam
Artículos sobre genética y reproducción en cerdos: selección genética, genómica, inseminación artificial, uso de hormonas...
Compara los datos productivos, calcula el número de plazas para cerdas, transición y cebo y visualiza tus tareas sobre el calendario según cada tipo de MEB.
Calcula las entradas de cerdas necesarias en una granja activa, una granja que inicia la actividad o una granja que amplía
Herramienta para comparar los datos reproductivos de tu granja con la base de datos BDporc y ver la evolución de los parámetros reproductivos de BDporc
Un diccionario sobre terminología específica de la porcicultura
Utiliza esta herramienta para investigar porque tu tasa de partos es inferior a la ideal. Da click en el diagrama de flujo o en los botones dentro del texto para navegar por las distintas partes de la herramienta.
Un resumen semanal de las novedades de 3tres3 Latam
Manejo y gestión de las granjas porcícolas y organización del trabajo en cada una de las fases de producción.
Compara los datos productivos, calcula el número de plazas para cerdas, transición y cebo y visualiza tus tareas sobre el calendario según cada tipo de MEB.
Calcula las entradas de cerdas necesarias en una granja activa, una granja que inicia la actividad o una granja que amplía
Herramienta para comparar los datos reproductivos de tu granja con la base de datos BDporc y ver la evolución de los parámetros reproductivos de BDporc
Aquí puedes comparar diversos objetos o juguetes usados como material de enriquecimiento para prevenir el estrés y las mordeduras de cola en cerdos.
Un diccionario sobre terminología específica de la porcicultura
Un resumen semanal de las novedades de 3tres3 Latam
Información sobre el diseño de instalaciones para granjas porcícolas, equipos y materiales para granjas y una herramienta para compararlos
Biocheck.UGent es un sistema de puntuación científico independiente, basado en riesgos, para evaluar la calidad de su bioseguridad en la granja.
Calculadora de la Huella Ambiental a lo largo de la cadena de valor del sector porcino
¿Qué comedero se adapta mejor a mis necesidades? Aquí puedes comparar las características de diversos tipos de comederos comerciales.
¿Qué bebedero se adapta mejor a mis necesidades? Aquí puedes comparar las características de diversos bebederos comerciales.
Un diccionario sobre terminología específica de la porcicultura
Utiliza esta herramienta para investigar que estrategia de gestión de excretas se adapta mejor a tu situación. Da click en el diagrama de flujo o en los botones dentro del texto para navegar por las distintas partes de la herramienta.
Un resumen semanal de las novedades de 3tres3 Latam

Un resumen semanal de las novedades de 3tres3 Latam
Accede y apúntate a la lista

La Comisión Europea lanza EU-JAMRAI 2 para dar una respuesta unificada a la resistencia a los antibióticos.

El Ministerio de Desarrollo Agropecuario (MIDA) conmemoró el pasado 25 de enero de 2024, 51 años al servicio del sector agropecuario.

La Secretaría de Agricultura y el Departamento de Agricultura de EE.UU refrendaron su compromiso de trabajar en favor del fortalecimiento de la sanidad animal y la prevención de enfermedades en el sector pecuario, a través de la Comisión México–EE.UU para la Prevención de la Fiebre Aftosa y otras Enfermedades Exóticas de los Animales (CPA).

El subsecretario de Alimentos, Bioeconomía y Desarrollo Regional, firmó la Disposición 2/2024 publicada en el Boletín Oficial.

El nuevo organismo incorpora el concepto de 'One Health-una sola salud', que implica que la salud de las personas está interrelacionada con la salud ambiental y con la animal.

El aumento del número de brotes de fiebre aftosa en varios países del norte de África y la reciente detección del serotipo SAT 2 en Argelia aumentan el riesgo de entrada de la enfermedad.

Bienvenido a 3tres3
Conecta, comparte y relaciónate con la mayor comunidad de profesionales del sector porcino.
¡Ya somos 192228 Usuarios!
Regístrate¿Ya eres miembro?



Se presentó la nueva infraestructura de SENASA valorizada en más de PEN 16 millones que beneficiará a 149 000 ciudadanos

El rol clave que cumple el Senasa en el cuidado de los estatus zoofitosanitarios y exportaciones agroalimentarias de Argentina.

El Senasa establece mediante su Resolución 45/2024 publicada hoy en el Boletín oficial los pasos a seguir para realizar esta técnica.

Montenegro informa de la primera aparición de peste porcina africana en el país, encontrada en jabalíes.

Presentamos la evolución de la peste porcina africana en los diferentes países europeos desde la confirmación en 2014 y con datos actualizados a 2023.

El Senasa supervisa la aplicación del plan de saneamiento por la enfermedad de Aujeszky en granjas porcinas ubicadas en la provincia de Córdoba


El secretario de Agricultura y Desarrollo Rural, Víctor Villalobos Arámbula, sostuvo un encuentro bilateral con el ministro de Agricultura y Asuntos Rurales de China, Tang Renjian.

La Comisión México-Estados Unidos para la Prevención de la Fiebre Aftosa y otras Enfermedades Exóticas de los Animales (CPA) reafirmaron su compromiso por mantener su asociación técnico–científica, con el fin de disminuir el riesgo de ingreso y dispersión de plagas y enfermedades que pudieran poner en riesgo la ganadería de la región de América del Norte.
La Secretaría de Agricultura opera a nivel nacional nueva estrategia para frenar la resistencia a los antimicrobianos y sus acciones están alineadas a las recomendaciones de las OMS, la FAO, la OMSA y el UNEP, bajo el concepto Una Salud.

El Senasa aprobó primera vacuna atenuada contra la enfermedad que afecta a porcinos.

Ya no será necesario realizar muestreos para detectar la peste porcina africana en cerdos enfermos dado que Bélgica no ha tenido animales infectados desde 2020.

El Senasica aplica recursos federales para proteger la producción agroalimentaria de plagas y enfermedades de origen vegetal y animal y mejorar las condiciones de inocuidad de las unidades de producción.



Se han eliminado varias restricciones en la zona exterior recién delimitada.

El Servicio Nacional de Sanidad Agropecuaria e Inocuidad Alimentaria (SENASAG), brazo operativo del Ministerio de Desarrollo Rural y Tierras, velando por la salud de la población en estas fiestas de fin de año, presentó la lista oficial de planteles de beneficio autorizados para el faenado de bovinos y porcinos.

El objetivo es combatir la superpoblación de jabalíes, una especie exótica e invasora sin depredadores naturales que ha causado daños a la agricultura de Santa Catarina.

La quinta fase de la campaña contra la PPC continúa hasta el 12 de diciembre.

Italia a la cabeza de los países europeos en la disminución del uso de antimicrobianos.

La Secretaría de Asistencia Técnica y Defensa Agraria (Sada), a través de la Agencia de Defensa Agraria (Adapi), confirmó otro brote de Peste Porcina Clásica (PPC) en el estado de Piauí.


Un resumen semanal de las novedades de 3tres3 Latam
Accede y apúntate a la lista